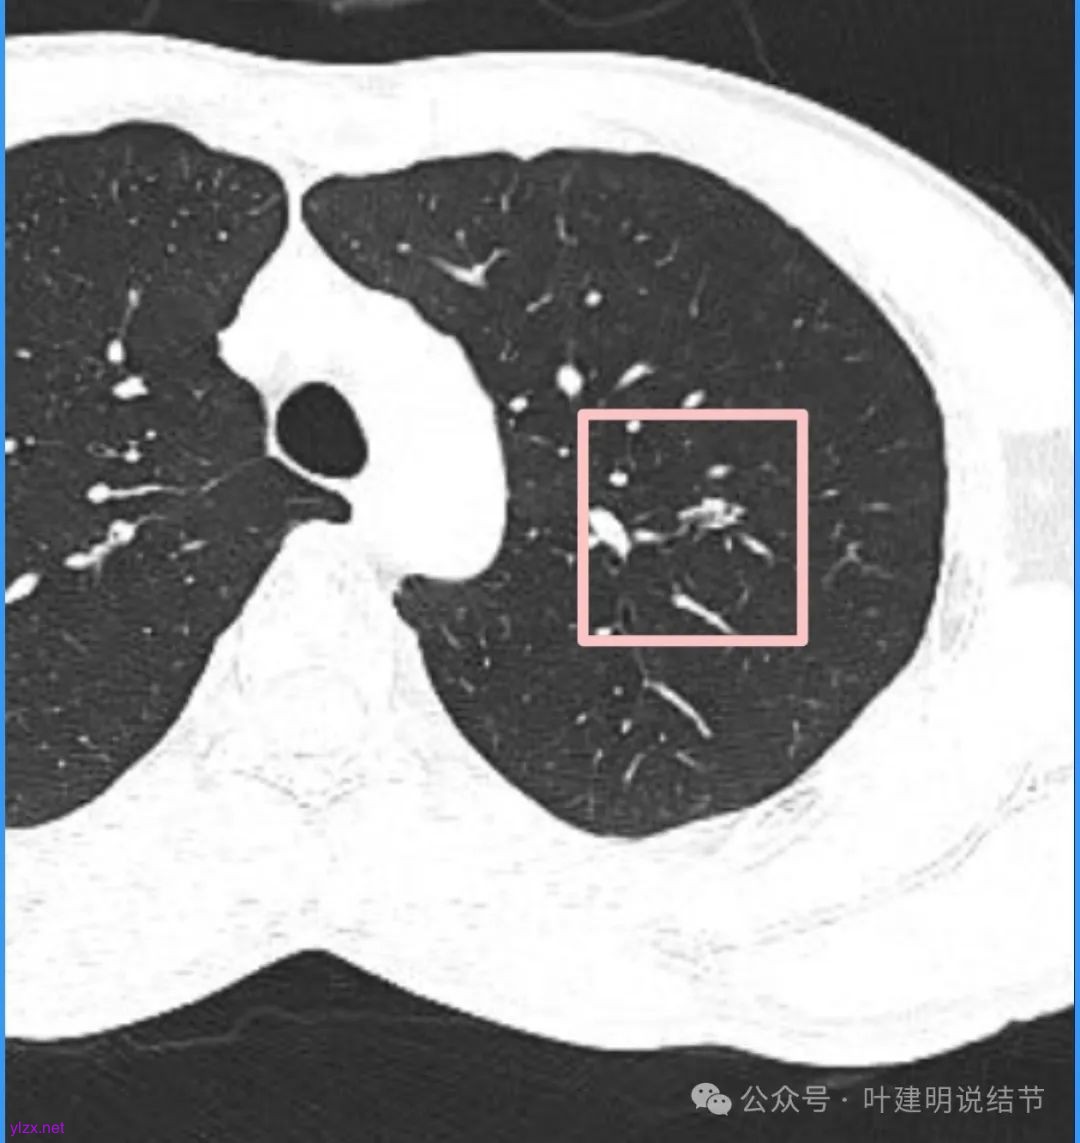
图片
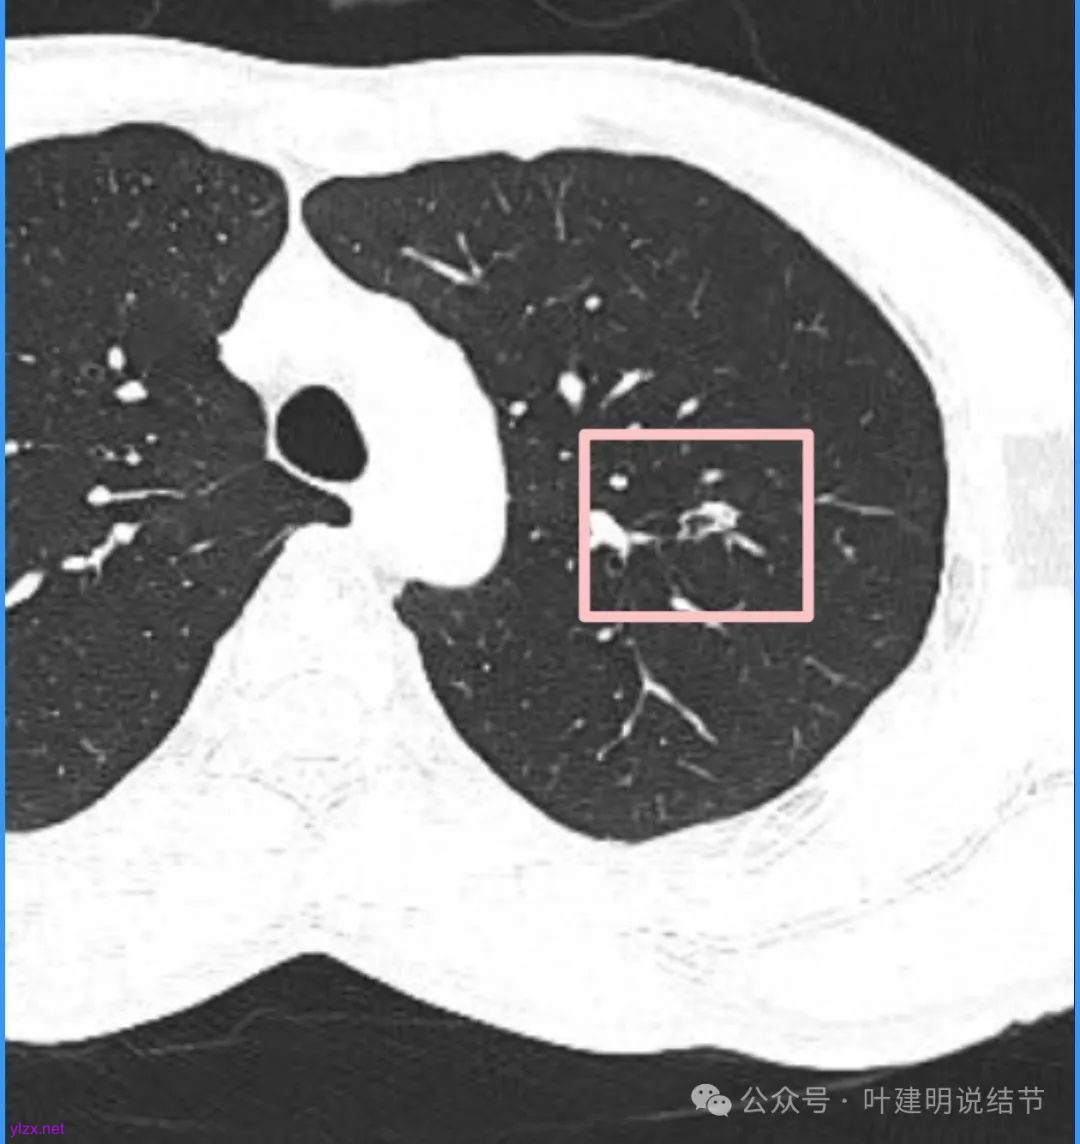
图片
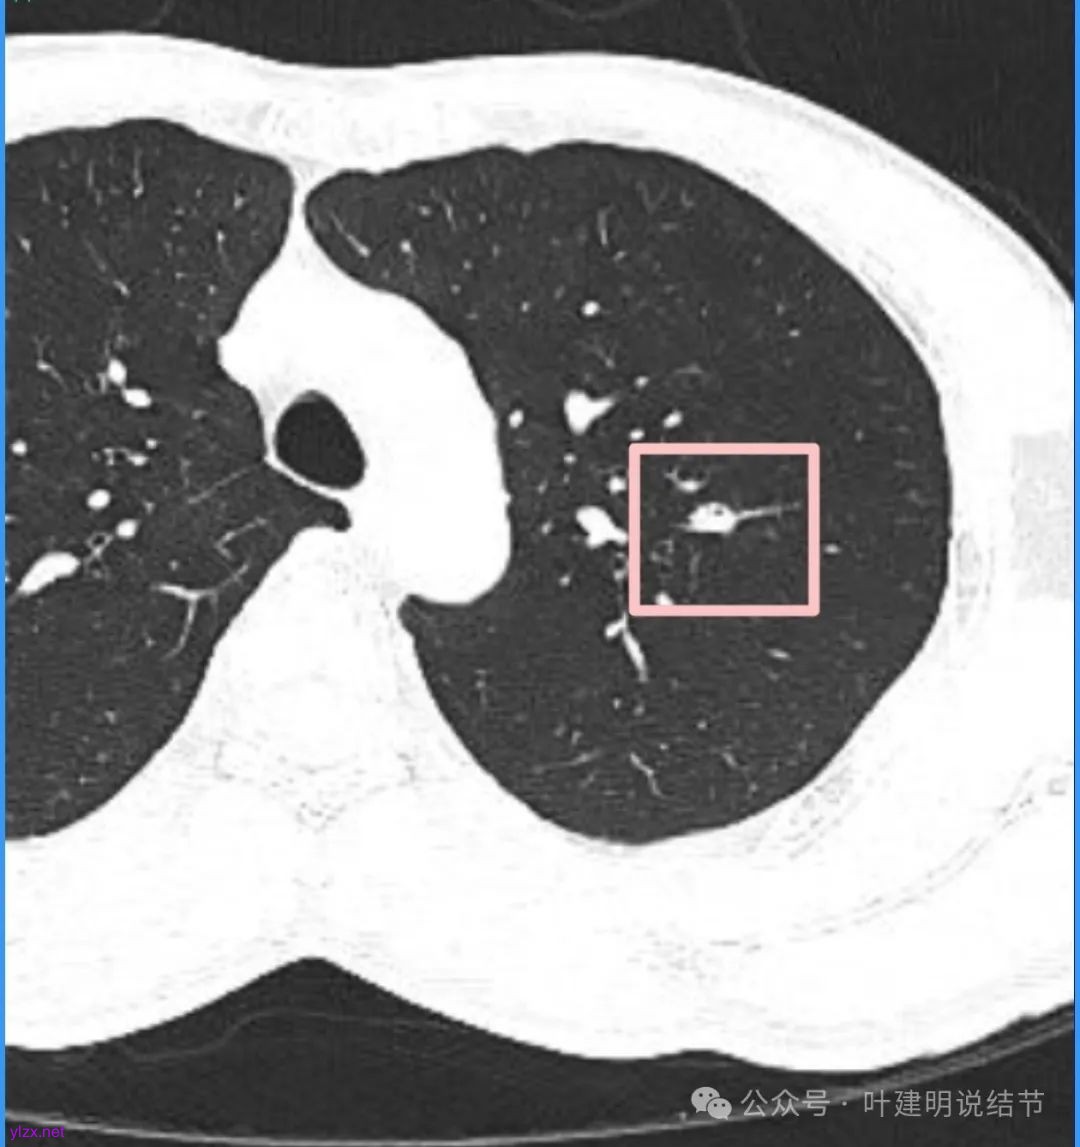
图片
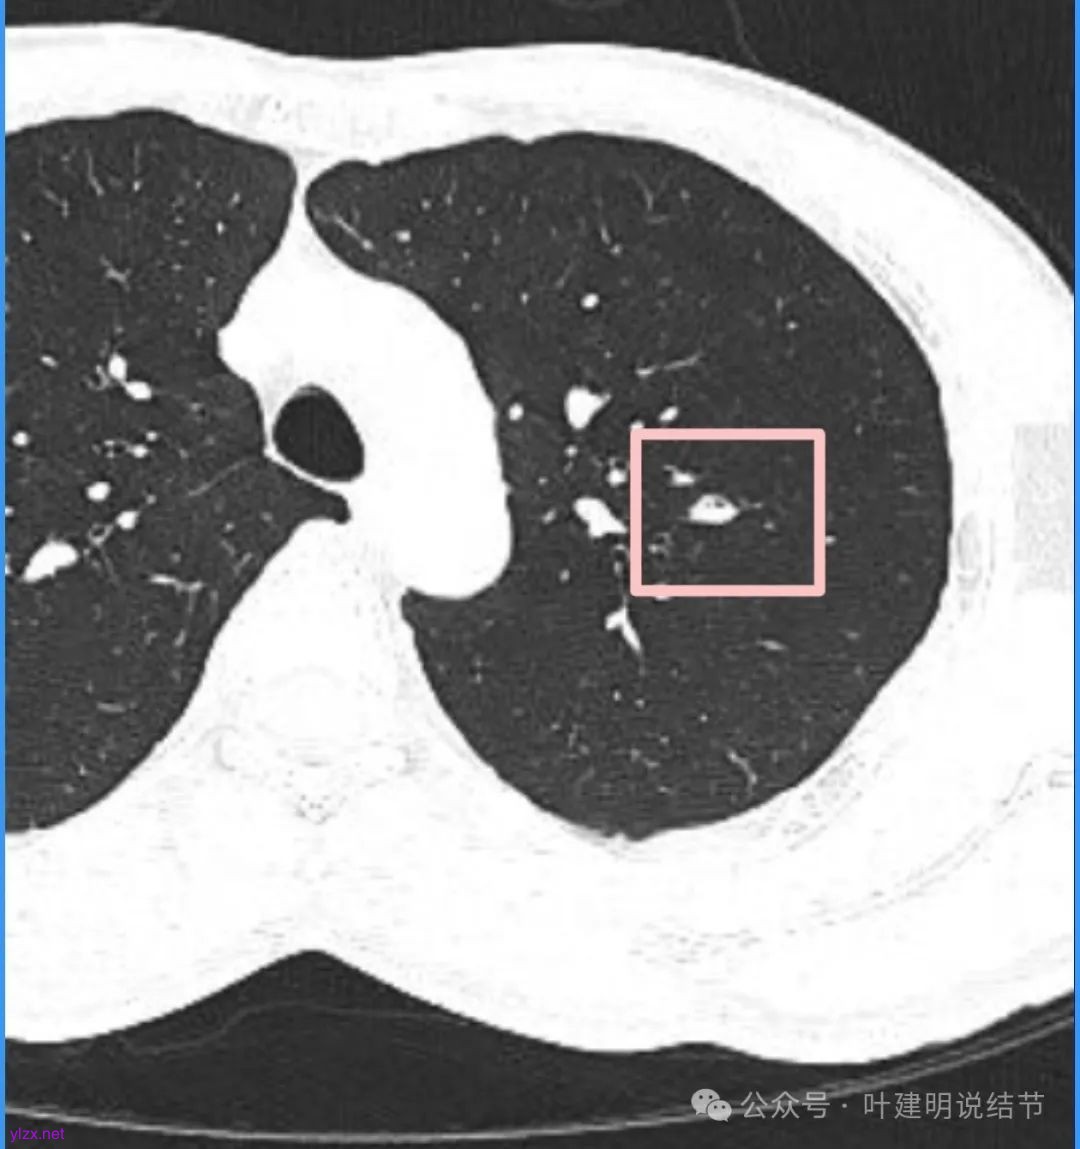
图片
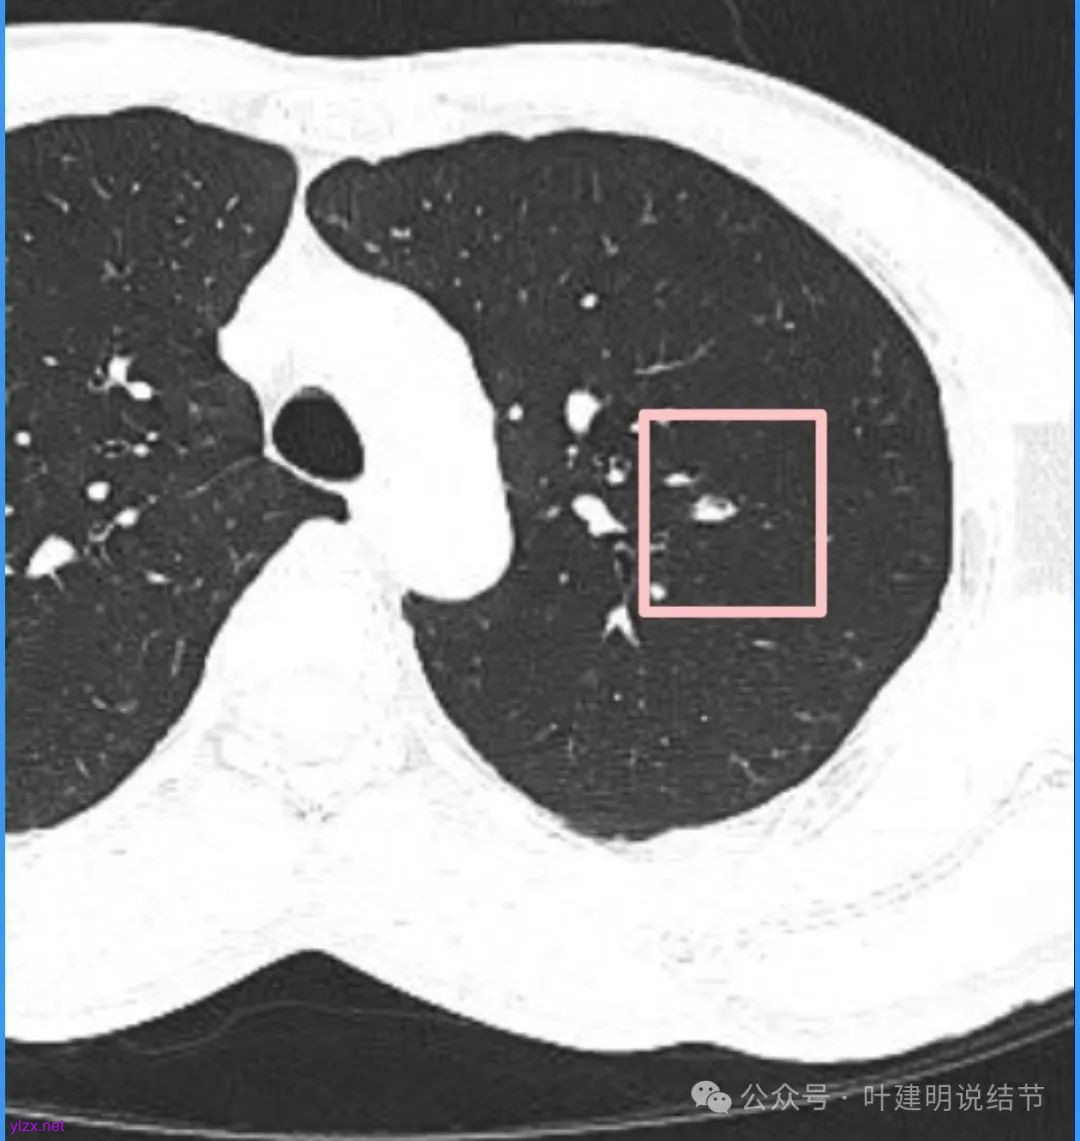
图片

问诊分析:肺结节有血管弯征支气管扭曲及血管征,但位置不好,切怕良性不切怕恶性,怎么办?
时间:2025-04-09 12:10:09 热度:37.1℃ 作者:网络
前言:肺结节如果影像表现典型,明显恶性且风险较高,当然也容易下定决心手术。但若病灶有恶性影像特征,却又不太典型,有良性的迹象但也不放心,这时候若再加上位置不在边上,无法楔形切除,那么较大范围的切除,病理若良性则亏大了;事实上若是恶性则随访又可能耽误病情。真提很纠结的事。今天分享的这位结友,要我说定良性还是恶性,我也下不了结论,但我是权衡后倾向再随访比较稳妥。大家觉得呢?
病史信息:
基本信息:
男性, 37岁 。
主诉:
体检发现肺部实性结节近半年+轻微胸痛、偶咳白痰。
现病史:
患者诉于2024年11月体检发现肺部结节,于2025-3-10复查。纸质报告上那个医生讲没问题。但是他后来打开电脑仔细看了片子以后他告诉我要特别小心,说实性结节0.8*0.6,有血管穿行、有一点空泡、有一点毛刺。
曾就诊医院:
某医科大学第一附属医院
希望获得的帮助:
1.分析结节的性质。2.分析前后两次CT的变化。3.判断是否有胸膜牵拉。4.风险综合评估。5.是否属于原位癌或者是浸润性的?6.有无手术的必要?
影像展示与分析:
我们先来看2025年3月时的影像:

病灶密度不均,混合密度的样子,相应的细支气管有扭曲略显扩张。

边缘较为毛糙不平,灶内密度杂乱,细支气管穿行,整体轮廓较清。

邻近血管受结节影响,略向病灶侧弯,病灶处是扩张的细支气管还是灶内的空泡征?

有血管征,整体轮廓与边界较清,灶内有蜂窝状。

血管穿过病灶,灶内多个小空泡,整体轮廓较清。

蓝色部分似乎是血管,但似乎又是增厚的支气管壁,局部细支气管扩张。

特别上上图边缘些的层面,蓝色箭头所指的实性明显又像位于扩张细支气管内或与支气管壁一块的样子。
再看看近半年前2024年11月时的影像:

我们发现一是病灶与25年3月的几乎没有区别,二是原来蓝色箭头处不太像血管,而是结节边缘的一部分,而结节灶内又是有扩张支气管的。
我的回复:
左肺上叶这个病灶总体上来讲2025年3月的与2024年11月份相比没有显著进展。我们逐层从细节上去分析,会发现:1、病灶开始出现的层面就有临近的支气管扭曲变形,这些人用肿瘤导致的牵拉不能解释,反而用细支气管扩张伴慢性炎容易解释;2、病灶内部仍然多个层面都有见到扩张的细支气管,可是如果是肿瘤,与导致细支气管扩张相应的病灶本身的收缩力或者边缘毛刺又不明显;3、病灶边缘基本上都比较光滑平直,没有像外周浸润性生长的枫叶或者毛刺;4、虽然有血管贴边或者进入,但是说不上显著的血管异常增粗;5、整体来讲病灶实性成分密度过高,随访对比进展不明显,用结节是恶性不太能够解释相应的影像表现,所以我倾向于考虑是细支气管扩张伴有周围慢性炎或者肉芽肿性炎。至少从风险高低的角度来看,几个月的间隔没有明显进展的情况下加上位置又不好,如果手术需要切除范围比较多,所以应该在随访观察比较稳妥,可以考虑半年复查对比。意见供参考!
感悟:
这个病灶到底是什么性质,目前仍无确切定论,但年纪这么轻,才37岁,而位置却靠肺门部较近,是没有办法简单的楔形切除或较少的肺段切除来去除病灶,需要固有段甚至左上叶切除。而若最后却是良性,当然是不划算的。而若暂时不切,会不会耽误病情呢?我的考虑是已经约半年确定病灶本身是没有进展的,那至少说明不会是恶性程度高的类型,此前近半年,下次仍半年应该也不至于就突然爆发性进展并转移。所以权衡之后,我才给出仍再随访的建议。当然也可以选择查下PET-CT试试,但也不是确诊的手段;当然也可以气管镜查下,若能明确也是好的。我总觉得,在影像较为典型并较为明确可判断性质时,是否处理要看风险大小;在影像表现不太典型而良恶性举棋不定时,交给时间,谨慎随访对比或许是更为稳妥的策略,时间会给我们答案。

